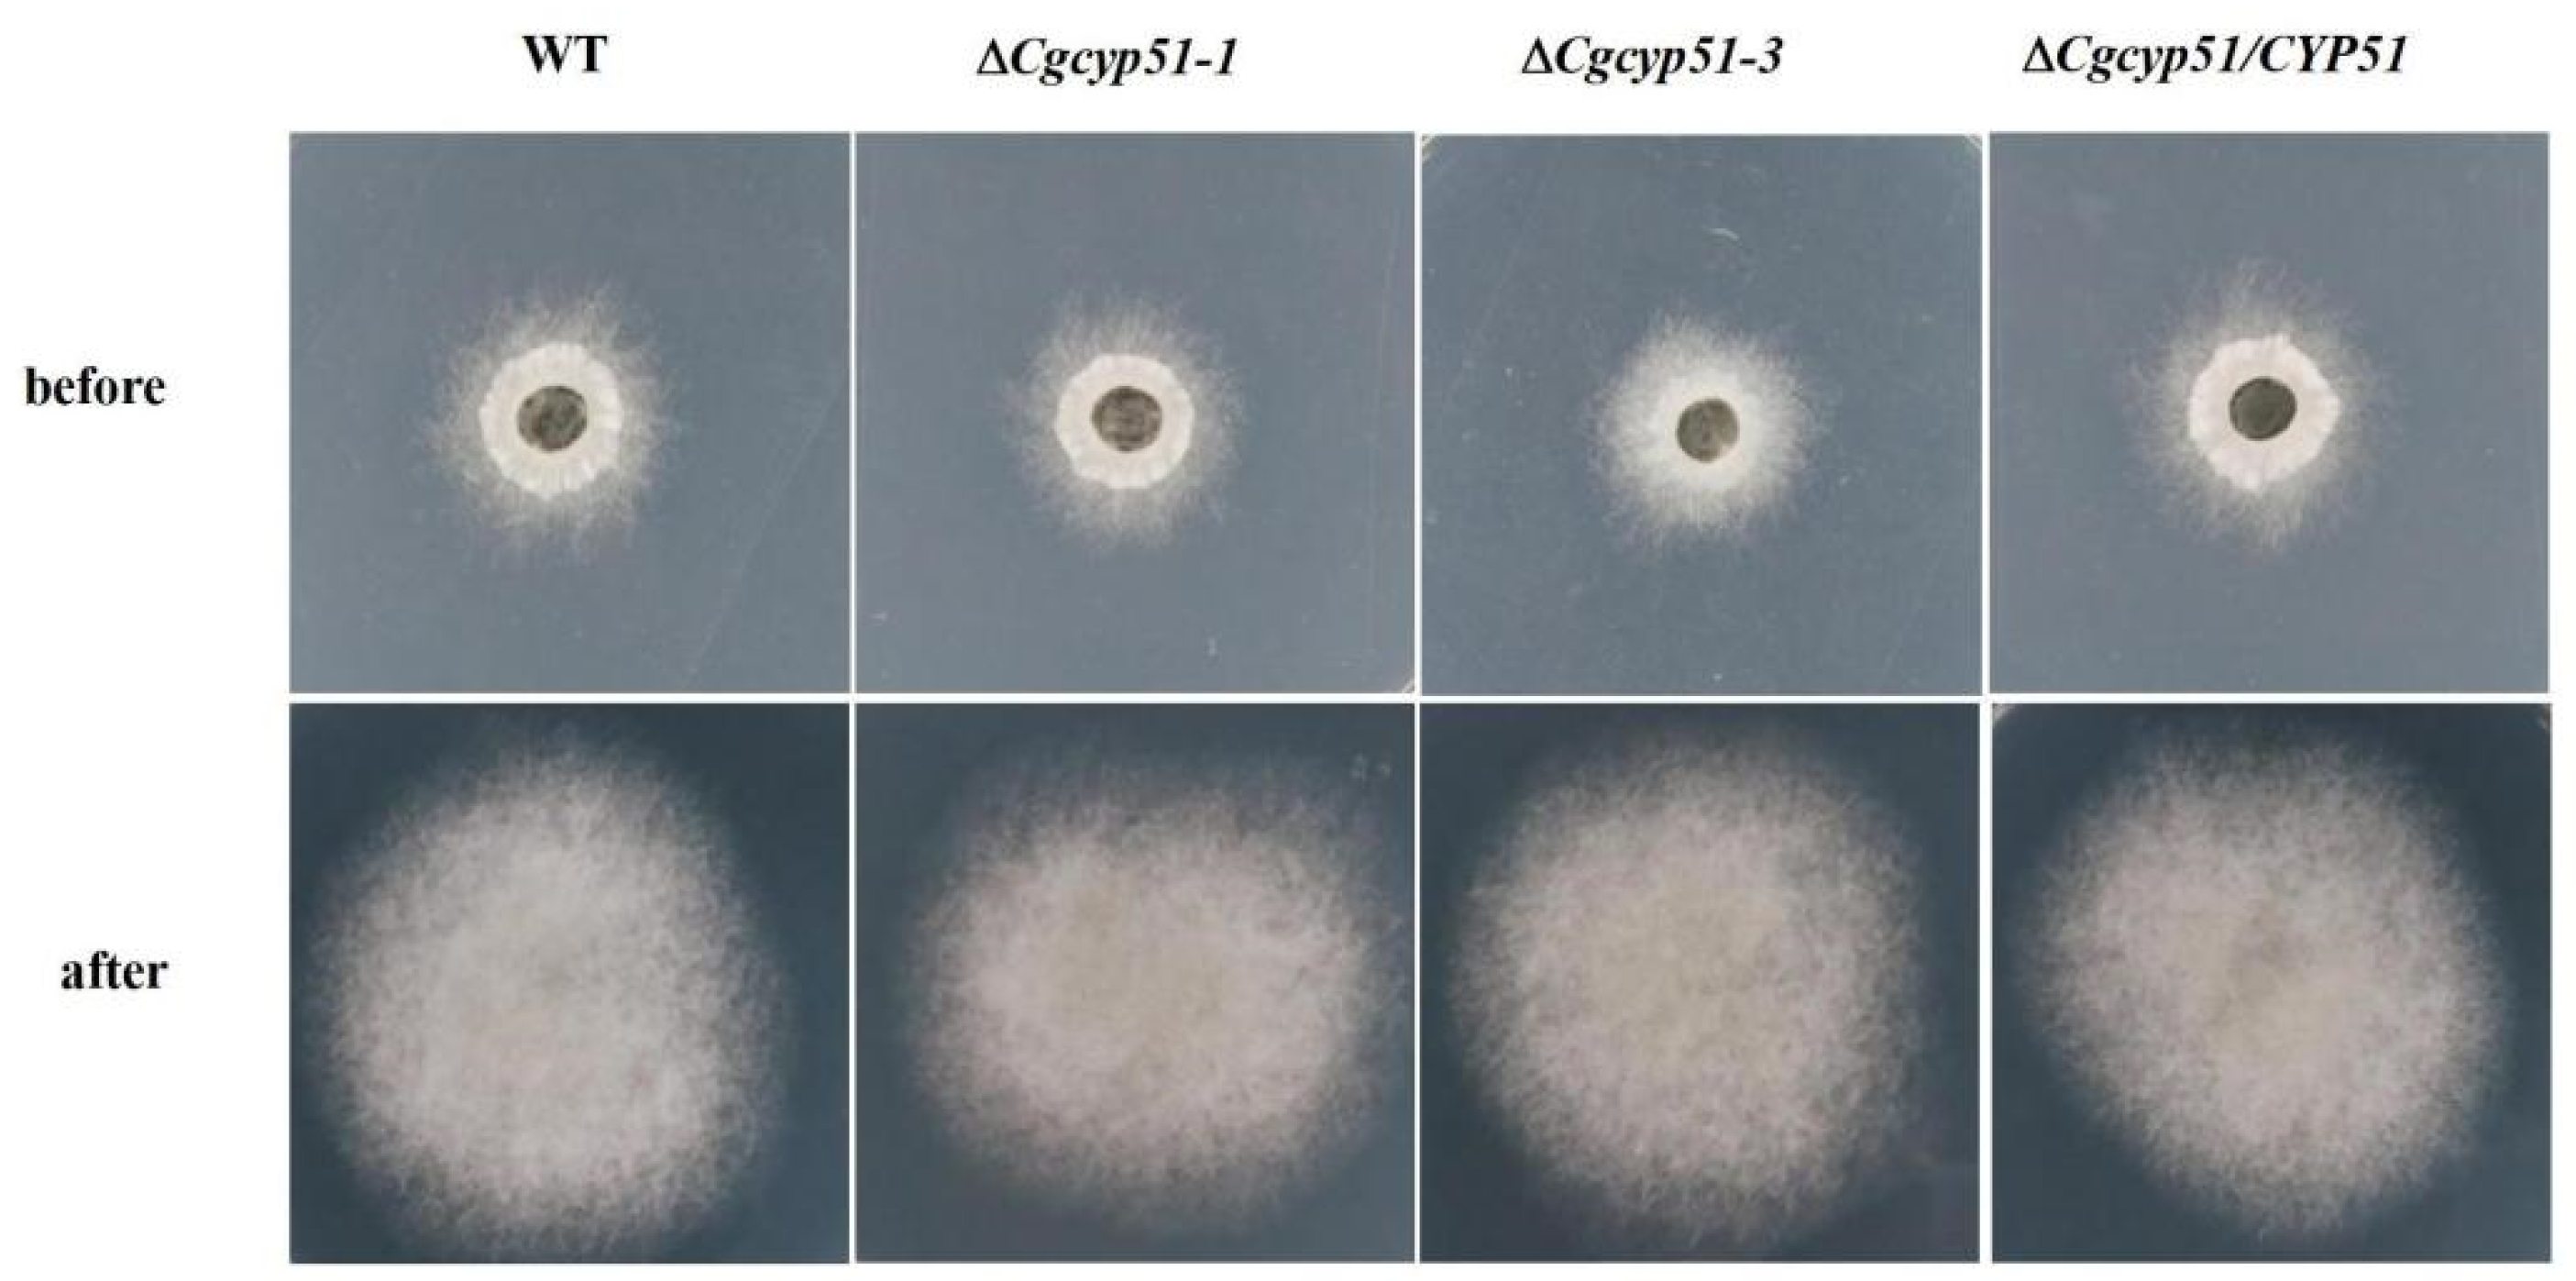
Forests 15 01888 g006
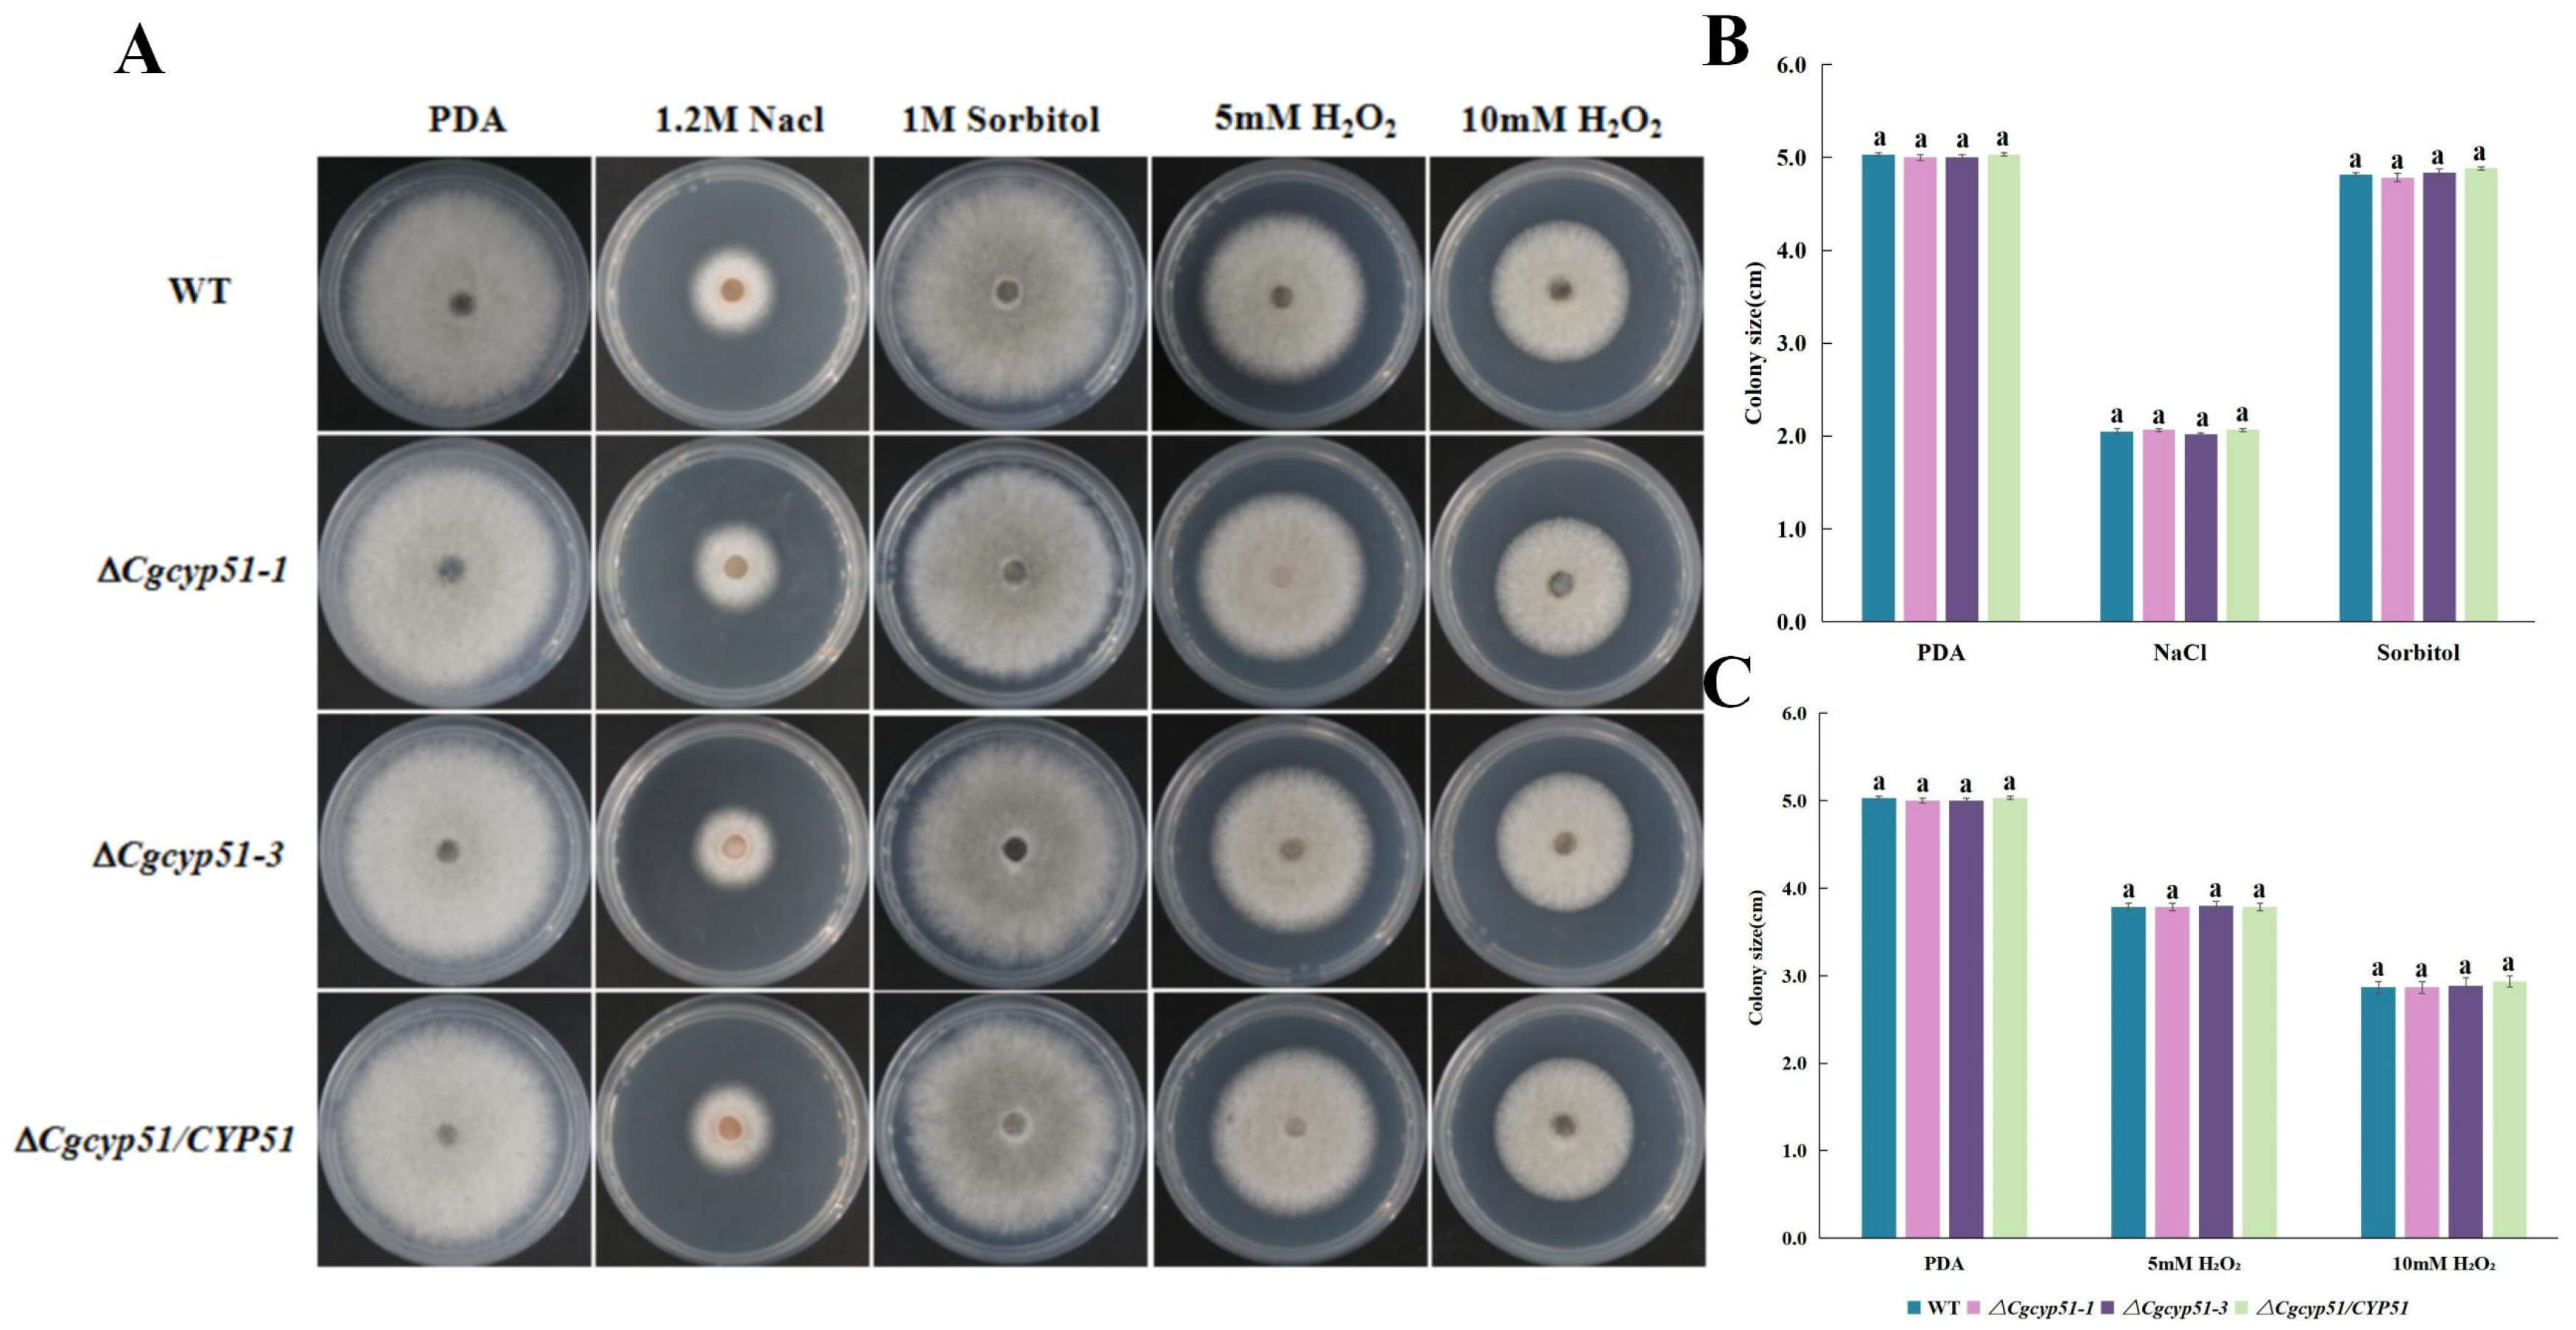
Forests 15 01888 g007

Functional Characterization of the Sterol-Synthesis-Related Gene CgCYP51 in the Poplar Anthracnose-Causing Fungus Colletotrichum gloeosporioides
Abstract
1. Introduction
2. Materials and Methods
2.1. Experimental Strains and Culture Methods
2.2. Molecular Cloning of CgCYP51
2.3. Knockout Mutants and Complementary Strains
2.4. Growth Test
2.5. Conidial Germination and Development of Appressorium
2.6. Appressorium Turgor Pressure Test
2.7. Scanning Electron Microscopy
2.8. Cellophane Membrane Penetration Test
2.9. Determination of Stress Sensitivity
2.10. Pathogenicity Test
3. Results
3.1. Characterization and Deletion of CgCYP51 in C. gloeosporioides
3.2. CgCyp51 Does Not Regulate C. gloeosporioides Mycelial Growth
3.3. CgCyp51 Regulates Appressorium Formation and Melanization
3.4. CgCyp51 Regulates C. gloeosporioides Appressorium Turgor Pressure
3.5. CgCyp51 Regulates Appressorium Mucus Production and Penetration Pore Formation
3.6. CgCyp51 Does Not Affect the Ability of Colletotrichum gloeosporioides Mycelia to Penetrate a Cellophane Membrane
3.7. CgCYP51 Knockout Mutant Responses to High Osmotic and Oxidative Stresses
3.8. Determination of the Sensitivity of CgCYP51 Knockout Mutants to Sterol Biosynthesis Inhibitors
3.9. CgCyp51 Regulates Colletotrichum gloeosporioides Pathogenicity
4. Discussion
5. Conclusions
Supplementary Materials
Author Contributions
Funding
Data Availability Statement
Conflicts of Interest
References
- He, W.; Yang, W.; Shen, R.X. Preliminary study on anthracnose of Beijing poplar. For. Pests Dis. Newsl. 1991, 3, 7–9. [Google Scholar]
- Li, S.M.; Wang, Y.L.; Huang, D.H.; Tian, C.M. Establishment of genetic transformation of poplar anthracnose protoplasts and expression of green fluorescent protein. For. Sci. 2013, 49, 121–127. [Google Scholar]
- De Silva, D.D.; Crous, P.W.; Ades, P.K.; Hyde, K.D.; Taylor, P.W.J. Life styles of Colletotrichum species and implications for plant biosecurity. Fungal Biol. Rev. 2017, 31, 155–168. [Google Scholar] [CrossRef]
- Zhang, X.L. Histopathology of Colletotrichum gloeosporioides Infesting Leaves of Beijing Poplar; Beijing Forestry University: Beijing, China, 2018. [Google Scholar]
- Chethana, K.T.; Jayawardena, R.S.; Chen, Y.-J.; Konta, S.; Tibpromma, S.; Phukhamsakda, C.; Abeywickrama, P.D.; Samarakoon, M.C.; Senwanna, C.; Mapook, A.; et al. Appressorial interactions with host and their evolution. Fungal Divers. 2021, 110, 75–107. [Google Scholar] [CrossRef]
- Wang, K.T.; Wang, W.H.; Zhang, S.C. Research progress of Bacillus anthracis appressorium. Chin. Agron. Bull. 2007, 7, 265–270. [Google Scholar]
- Rocha, R.O.; Elowsky, C.; Pham, N.T.T.; Wilson, R. A. Spermine-mediated tight sealing of the Magnaporthe oryzae appressorial pore-rice leaf surface interface. Nat. Microbiol. 2020, 5, 1472–1480. [Google Scholar] [CrossRef]
- Zhou, D.Y.; Liu, Y.X.; Xie, D.X.; Huang, X.J.; Wei, W.; Guo, L.J.; Yang, L.Y.; Huang, J. S. Cloning and sequence analysis of ste12 gene from banana wilt. J. Trop. Crop. 2011, 32, 2298–2301. [Google Scholar]
- Wong Sak Hoi, J.; Dumas, B. Ste12 and Ste12-like proteins, fungal transcription factors regulating development and pathogenicity. Eukaryot. Cell 2010, 9, 480–485. [Google Scholar] [CrossRef]
- Park, G.; Xue, C.; Zheng, L.; Lam, S.; Xu, J.R. MST12 regulates infectious growth but not appressorium formation in the rice blast fungus Magnaporthe grisea. Mol. Plant Microbe Interact. 2002, 15, 183–192. [Google Scholar] [CrossRef]
- Li, F.H. Transcriptomic Analysis of the Transcription Factor CgSte12 and Functional Study of Its Regulatory Gene CgCyp51; Beijing Forestry University: Beijing, China, 2024. [Google Scholar]
- Li, F.H.; Lu, D.X.; Meng, F.L.; Tian, C.M. Transcription factor CgSte12 regulates pathogenicity by affecting appressorium structural development in the anthracnose-causing fungus Colletotrichum gloeosporioides. Phytopathology 2024, 114, 1832–1842. [Google Scholar] [CrossRef]
- Lepesheva, G.I.; Waterman, M.R. Sterol 14α-demethylase cytochrome P450 (CYP51), a P450 in all biological kingdoms. Biochim. Biophys. Acta Gen. Subj. 2007, 1770, 467–477. [Google Scholar] [CrossRef] [PubMed]
- Lepesheva, G.I.; Waterman, M.R. Structural basis for conservation in the CYP51 family. Biochim. Biophys. Acta Proteins Proteom. 2011, 1814, 88–93. [Google Scholar] [CrossRef] [PubMed]
- Waterman, M.R.; Lepesheva, G.I. Sterol 14α-demethylase, an abundant and essential mixed function oxidase. Biochem. Biophys. Res. Commun. 2005, 338, 418–422. [Google Scholar] [CrossRef] [PubMed]
- Lepesheva, G.I.; Waterman, M.R. CYP51—The omnipotent P450. Mol. Cell. Endocrinol. 2004, 215, 165–170. [Google Scholar] [CrossRef]
- Aoyama, Y.; Yoshida, Y.; Sato, R. Yeast cytochrome P-450 catalyzing lanosterol 14 alphademethylation. II. Lanosterol metabolism by purified P-450 (14) DM and by intact microsomes. J. Biol. Chem. 1984, 259, 1661–1666. [Google Scholar] [CrossRef]
- Yan, X.; Ma, W.B.; Li, Y.; Wang, H.; Que, Y.W.; Ma, Z.H.; Talbot, N.J.; Wang, Z.Y. A sterol 14α-demethylase is required for conidiation, virulence and for mediating sensitivity to sterol demethylation inhibitors by the rice blast fungus Magnaporthe oryzae. Fungal Genet. Biol. 2011, 48, 144–153. [Google Scholar] [CrossRef]
- Fan, J.; Urban, M.; Parker, J.E.; Brewer, H.C.; Kelly, S.L.; Hammond-Kosack, K.E.; Fraaije, B.A.; Liu, X.; Cools, H.J. Characterization of the sterol 14α-demethylases of Fusarium graminearum identifies a novel genus-specific CYP51 function. New Phytol. 2013, 198, 821–835. [Google Scholar] [CrossRef]
- Mellado, E.; Garcia-Effron, G.; Buitrago, M.J.; Alcazar-Fuoli, L.; Cuenca-Estrella, M.; Rodriguez-Tudela, J.L. Targeted gene disruption of the 14-α sterol demethylase (cyp51A) in Aspergillus fumigatus and its role in azole drug susceptibility. Antimicrob. Agents Chemother. 2005, 49, 2536–2538. [Google Scholar] [CrossRef]
- Meng, F.L.; Tian, C.M. Gene family expansion during the adaptation of Colletotrichum gloeosporioides to woody plants. J. Fungi 2023, 9, 1185. [Google Scholar] [CrossRef]
- Tamura, K.; Stecher, G.; Peterson, D.; Filipski, A.; Kumar, S. MEGA6: Molecular evolutionary genetics analysis version 6.0. Mol. Biol. Evol. 2013, 30, 2725–2729. [Google Scholar] [CrossRef]
- Patnaik, S.R.; Raghupathy, R.K.; Zhang, X.; Mansfield, D.; Shu, X. The role of RPGR and its interacting proteins in ciliopathies. J. Ophthalmol. 2015, 2015, 414781. [Google Scholar] [CrossRef] [PubMed]
- Wilson, R.A.; Gibson, R.P.; Quispe, C.F.; Littlechild, J.A.; Talbot, N.J. An NADPH-dependent genetic switch regulates plant infection by the rice blast fungus. Proc. Natl. Acad. Sci. USA 2010, 107, 21902–21907. [Google Scholar] [CrossRef] [PubMed]
- Wang, X.L. Functional Analysis of CgMk1 MAPK and Upstream Receptor Proteins in Populus Anthracis; Beijing Forestry University: Beijing, China, 2021. [Google Scholar]
- Yang, J.Y.; Liao, M.J.; Yang, S. Progress of sterol 14α-demethylase (CYP51). J. Bioeng. 2008, 24, 1681–1688. [Google Scholar]
- Liu, X.; Yu, F.; Schnabel, G.; Wu, J.; Wang, Z.; Ma, Z. Paralogous cyp51 genes in Fusarium graminearum mediate differential sensitivity to sterol demethylation inhibitors. Fungal Genet. Biol. 2011, 48, 113–123. [Google Scholar] [CrossRef]
- Da Silva Ferreira, M.; Colombo, A.; Paulsen, I.; Ren, Q.; Wortman, J.; Huang, J.; Goldman, M.H.; Goldman, G.H. The ergosterol biosynthesis pathway, transporter genes, and azole resistance in Aspergillus fumigatus. Med. Mycol. 2005, 43 (Suppl. S1), S313–S319. [Google Scholar] [CrossRef]
- Wang, J.; Shi, D.; Wei, L.; Chen, W.; Ma, W.; Chen, C.; Wang, K. Mutations at sterol 14α-demethylases (CYP51A &B) confer the DMI resistance in Colletotrichum gloeosporioides from grape. Pest Manag. Sci. 2020, 76, 4093–4103. [Google Scholar]
- Cai, L.; Hyde, K.; Taylor, P.; Weir, B.S.; Waller, J.M.; Abang, M.M.; Zhang, J.Z.; Yang, Y.L.; Phoulivong, S.; Liu, Z.Y.; et al. A polyphasic approach for studying Colletotrichum. Fungal Divers. 2009, 39, 183–204. [Google Scholar]
- Duan, Z.B.; Gao, Q.; Lv, D.D.; Shi, S.H.; Wang, C.S. Differentiation of scarab Metarhizium anisopliae appressorium and its association with cyclic adenosine monophosphate cAMP. J. Mycol. 2009, 28, 712–717. [Google Scholar]
- St Leger, R.J.; Joshi, L.; Bidochka, M.J.; Rizzo, N.W.; Roberts, D.W. Biochemical characterization and ultrastructural localization of two extracellular trypsins produced by Metarhizium anisopliae in infected insect cuticles. Appl. Environ. Microbiol. 1996, 62, 1257–1264. [Google Scholar] [CrossRef]
- Leger, R.S.; Goettel, M.; Roberts, D.W.; Staples, R.C. Prepenetration events during infection of host cuticle by Metarhizium anisopliae. J. Invertebr. Pathol. 1991, 58, 168–179. [Google Scholar] [CrossRef]
- Mei, L.; Wang, X.; Yin, Y.; Tang, G.; Wang, C. Conservative production of galactosaminogalactan in Metarhizium is responsible for appressorium mucilage production and topical infection of insect hosts. PLoS Pathog. 2021, 17, e1009656. [Google Scholar] [CrossRef] [PubMed]
- Lan, H.Y.; Chen, Z.H. Morphological changes, physiological and biochemical mechanisms and gene regulation in plant-pathogen fungi interactions. Bot. Bull. 1999, 1, 345–351. [Google Scholar]
- Zhang, Y.; An, B.; Wang, W.; Zhang, B.; He, C.; Luo, H.; Wang, Q. Actin-bundling protein fimbrin regulates pathogenicity via organizing F—Actin dynamics during appressorium development in Colletotrichum gloeosporioides. Mol. Plant Pathol. 2022, 23, 1472–1486. [Google Scholar] [CrossRef] [PubMed]

Disclaimer/Publisher’s Note: The statements, opinions and data contained in all publications are solely those of the individual author(s) and contributor(s) and not of MDPI and/or the editor(s). MDPI and/or the editor(s) disclaim responsibility for any injury to people or property resulting from any ideas, methods, instructions or products referred to in the content. |
© 2024 by the authors. Licensee MDPI, Basel, Switzerland. This article is an open access article distributed under the terms and conditions of the Creative Commons Attribution (CC BY) license (https://creativecommons.org/licenses/by/4.0/).
Share and Cite
Zhang, M.; Li, F.; Meng, F. Functional Characterization of the Sterol-Synthesis-Related Gene CgCYP51 in the Poplar Anthracnose-Causing Fungus Colletotrichum gloeosporioides. Forests 2024, 15, 1888. https://doi.org/10.3390/f15111888
Zhang M, Li F, Meng F. Functional Characterization of the Sterol-Synthesis-Related Gene CgCYP51 in the Poplar Anthracnose-Causing Fungus Colletotrichum gloeosporioides. Forests. 2024; 15(11):1888. https://doi.org/10.3390/f15111888
Chicago/Turabian StyleZhang, Manyang, Fuhan Li, and Fanli Meng. 2024. "Functional Characterization of the Sterol-Synthesis-Related Gene CgCYP51 in the Poplar Anthracnose-Causing Fungus Colletotrichum gloeosporioides" Forests 15, no. 11: 1888. https://doi.org/10.3390/f15111888
APA StyleZhang, M., Li, F., & Meng, F. (2024). Functional Characterization of the Sterol-Synthesis-Related Gene CgCYP51 in the Poplar Anthracnose-Causing Fungus Colletotrichum gloeosporioides. Forests, 15(11), 1888. https://doi.org/10.3390/f15111888

